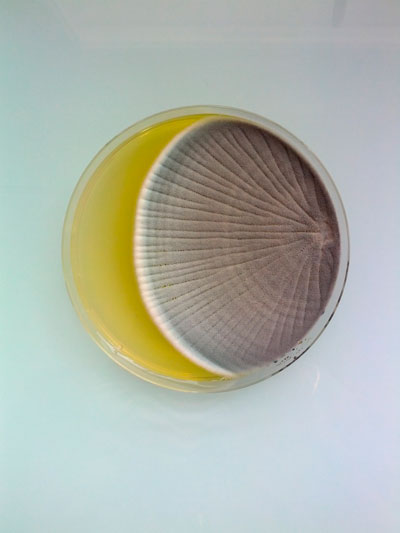

lundi 16 septembre 2013
Magical Contamination
Un projet photo de Antoine Bridier-Nahmias de boîtes de petri contenant des organismes comme des bactéries, champignons.
Papers, Please
Un jeu vidéo original qui vous met dans la peau d'un douanier devant faire des choix concernant les immigrés d'un pays frontalier. Réalisé par Lucas Pope.
lundi 9 septembre 2013
Late Night Work Club
Late Night Work Club presents GHOST STORIES from Late Night Work Club on Vimeo.
Late Night Work Club est un collectif d'animateurs ayant réalisé chacun une animation sur le thème Histoires de Fantômes, pendant leurs heures libres et sans financement. On retrouve notamment Scott Benson, Eamonn O'Neill, Dave Prosser, Alex Grigg et Charles Huettner.
Inscription à :
Commentaires (Atom)